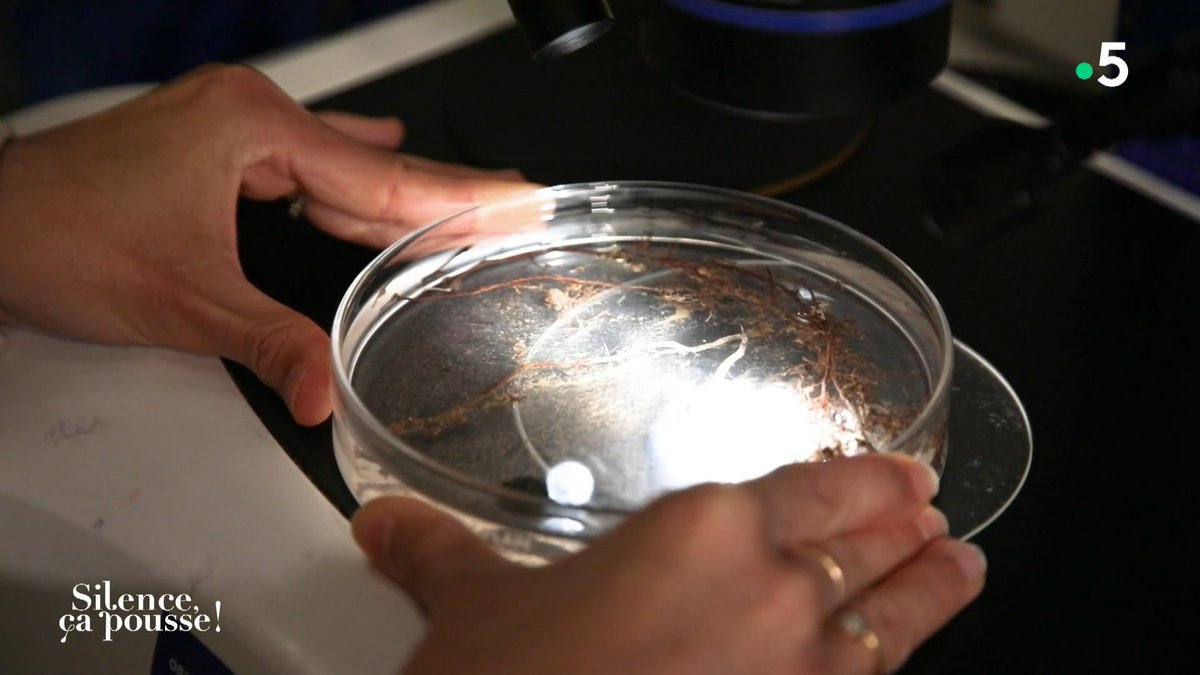
INRAE tweet media

Mina Vilayleck
1.1K posts

Mina Vilayleck
@MVilayleck
#communication #science #agriculture #alimentation #environnement #developpement #durable


Une 1ère en France! Les ateliers de la consultation publique #CORAE @Occitanie portés par la CRAO et par @INRAE_France sont lancés!!😊 À #Montpellier et à #Toulouse les groupes constitués sont à l’œuvre pour dialoguer et débattre sur l’#agriculture et l’alimentation de demain 👍

Inauguration du salon @sitevi aujourd’hui : auprès de nos viticulteurs, durement touchés par la crise, mais aussi auprès des filières qui œuvrent à la diversification, comme les producteurs d’olives et de pistaches, et tous les acteurs de la recherche, du machinisme et de la technique qui innovent à leur service. Aux côtés de tous ceux qui font vivre nos terroirs, nous continuons d’agir. 🍇🌿🇫🇷





#Biodiversité, de la Recherche à la Médiation (BRAM) : un consortium @CNRS, @umontpellier, @ird_fr, @EPHE_PSL avec @OFBiodiversite, @Montpellier3m et @montpellier_ est créé pour répondre collectivement aux enjeux de biodiversité en lien avec les activités humaines #CEFE











#INRAE présent au forum #emploi #public ! C’est aujourd’hui de 9h30 à 17h : on vous attend nombreux ;) @FranceTravail @Prefet34 @Occitanie @Montpellier3m @montpellier_

#festival À ta santé environnementale : c’est parti ! Masterclass de théâtre forum avec @MamadouDiol du Sénégal : imaginer des scénettes pour débattre des pollutions #sciencesrecherchesparticipatives @umontpellier @Fondationfrance @INRAE_DipSO @INRAE_France @ChristelleGram3